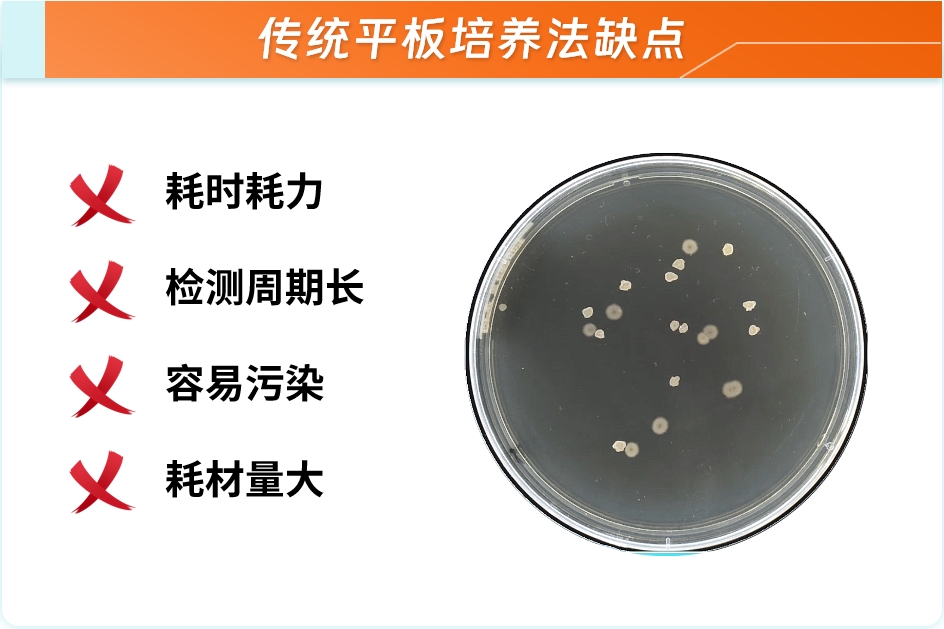
微信截圖_20240808101412.png

一、背景

在當今的食品工業中,飲料作為一種廣受歡迎的消費品,其安全性和質量標準受到消費者和監管機構的高度重視。飲料,包括但不限于瓶裝水、果汁、碳酸飲料、乳制品和功能性飲料等,由于其豐富的營養成分和適宜的水分條件,容易成為微生物生長的溫床。因此,對飲料進行微生物檢測是確保其安全性和延長保質期的關鍵步驟。
二、傳統平板培養法的缺點
傳統平板培養法是一種廣泛使用的微生物檢測技術,它通過將樣品涂抹或滴加在培養基上,然后觀察和計數生長的菌落來進行微生物分析。但存在檢測時間長、耗材量大、易受污染等風險。并且應對微生物污染,不能及時進行表征。
三、微生物快速檢測分析儀優勢

為應對這一挑戰,提高對產品的質量把控,泰林推出了微生物快速檢測分析儀,檢測飲料中微生物含量。
四、樣品測試實驗
微生物快速檢測對于早期預警系統非常重要,能夠識別潛在風險。為此泰林收集了幾種市面上常見的飲料,采用微生物快速檢測分析儀對其進行微生物檢測。

五、測試過程

(一)測試數據



1) 樣品1飲用水(蒸餾水):微生物濃度6AFU/10mL,惰性粒子濃度8444個/10mL;
2) 樣品2飲用水(礦泉水):微生物濃度2AFU/10mL,惰性粒子濃度4423個/10mL;
3) 樣品3茶類飲料(黃色):微生物濃度5AFU/10mL,惰性粒子濃度82988個/10mL;
4) 樣品4維生素飲料(黃色):微生物濃度1AFU/10mL,惰性粒子濃度29226個/10mL。
六、結論
泰林對市面上4種常見飲料進行了微生物快速檢測,實時、精準顯示了飲料中的微生物含量,為食品安全監管提供了一種高效、準確的檢測手段。通過這種技術,可以及時發現和控制微生物污染,保障消費者健康,同時為飲料生產商提供了改進產品質量的科學依據。


 EN
EN
